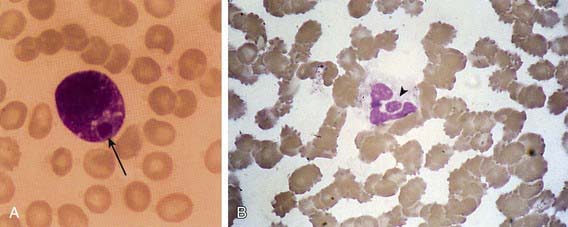
image

Chapter 223 Ehrlichioses and Anaplasmosis
Etiology
In 1987, clusters of bacteria confined within cytoplasmic vacuoles of circulating leukocytes (morulae), particularly mononuclear leukocytes, were detected in the peripheral blood of a severely ill patient with suspected Rocky Mountain spotted fever (RMSF). The etiologic agent of this case and other similar cases was found to resemble a canine pathogen in the genus Ehrlichia. In 1990, Ehrlichia chaffeensis was cultivated and identified as the predominant cause of “human ehrlichiosis.” Seroepidemiologic investigations showed that E. chaffeensis infections are transmitted by ticks and occur more often than RMSF in some geographic areas.
In 1994, the observation of other cases in which morulae were found only within circulating neutrophils and serology for E. chaffeensis was negative led to the recognition of another species. In these cases, serologic reactions were strongest to Ehrlichia phagocytophila and Ehrlichia equi, pathogens of ruminant and horse granulocytes, respectively. DNA of these bacteria was also found in the blood of infected persons. In 1996, the agent was cultivated in vitro; in 2001, the human agent and the 2 veterinary pathogens were unified into a single species and placed into the genus Anaplasma under the name Anaplasma phagocytophilum on the basis of genetic studies.
In 1996, a veterinary pathogen of canine neutrophils, Ehrlichia ewingii, was identified as the causative agent of some human infections initially thought to be due to E. chaffeensis because of the presence of morulae within circulating neutrophils. The infection is generally milder, but it can cause severe disease in children and adults with pre-existing immunosuppression, including organ transplant recipients or persons with HIV infection. Although not yet cultivated in vitro, it is serologically cross reactive with E. chaffeensis.
Although these infections are caused by bacteria assigned to various genera, the name ehrlichiosis has been applied to all. Human monocytic ehrlichiosis (HME) is used to describe disease characterized by infection of predominantly monocytes caused by E. chaffeensis, human granulocytic anaplasmosis (HGA) to describe disease of circulating neutrophils caused by Anaplasma phagocytophilum, and ewingii ehrlichiosis caused by E. ewingii (see Table 220-1).
All are tick-transmitted, small, obligate intracellular bacteria with gram-negative–type cell walls and are now classified in the Anaplasmataceae family. Neorickettsia (formerly Ehrlichia) sennetsu is another related bacterium that rarely causes human disease and is not transmitted by ticks. E. chaffeensis alters host signaling and transcription to cause the endosome to enter a receptor recycling pathway that avoids phagosome-lysosome fusion and allows the growth of a morula, an intravacuolar aggregate of bacteria. Little is known about the vacuoles in which A. phagocytophilum and E. ewingii grow. These bacteria are pathogens of phagocytic cells in mammals, and characteristically each species has a specific host cell affinity: E. chaffeensis and N. sennetsu infect mononuclear phagocytes, and A. phagocytophilum and E. ewingii infect neutrophils. Infection leads to direct modifications in function of the host cell that protect the bacterium from host defenses; yet, host immune and inflammatory reactions might in part account for many of the clinical manifestations seen in all forms of ehrlichiosis.
Epidemiology
Infections with E. chaffeensis occur across the southeastern, south central, and mid-Atlantic states in a distribution that parallels that of RMSF; cases have also been reported in northern California. Suspected cases with appropriate serologic and occasionally molecular evidence have been reported in Europe, Africa, and the Far East, including China and Korea. Human infections with E. ewingii have only been identified in the USA in areas where E. chaffeensis also exists, perhaps owing to a shared tick vector. Canine infections are documented in both sub-Saharan Africa and in South America.
Although the median age of patients with ehrlichiosis and anaplasmosis is generally older (>42 yr), many infected children have been identified. Little is known about the epidemiology of E. ewingii infections, although many patients have also been children. All infections are strongly associated with tick exposure and tick bites and are identified predominantly during May through September. Although both nymphal and adult ticks can transmit infection, nymphs are more likely to transmit disease, because they are most active during the summer.
Transmission
The predominant tick species that harbors E. chaffeensis and E. ewingii is Amblyomma americanum, the Lone Star tick. Additional vectors such as Dermacentor variabilis, the American dog tick, have not been proved but might explain the presence of HME outside the known range of A. americanum (see Fig. 220-1). The tick vectors of A. phagocytophilum are Ixodes, including I. scapularis (black-legged or deer tick) in the eastern USA (Fig. 220-1), I. pacificus (western black-legged tick) in the western USA, I. ricinus (sheep tick) in Europe, and I. persulcatus in Eurasia. Ixodes species ticks also transmit Borrelia burgdorferi, Babesia microti, and, in Europe, tick-borne encephalitis-associated flaviviruses. Co-infections with these agents and A. phagocytophilum have been documented in children and adults.
Ehrlichia and Anaplasma species are maintained in nature predominantly by horizontal transmission (tick to mammal to tick), because the organisms are not transmitted to the progeny of infected adult female ticks (transovarial transmission). The major reservoir host for E. chaffeensis is the white-tailed deer (Odocoileus virginianus), which is found abundantly in many parts of the USA. A reservoir for A. phagocytophilum in the eastern USA appears to be the white-footed mouse, Peromyscus leucopus. Deer or domestic ruminants may also have persistent asymptomatic infections, but the genetic variants in these reservoirs might not be infectious for humans. Efficient transmission requires persistent infections of mammals, long recognized in dogs with Ehrlichia canis, ruminants with A. phagocytophilum, and other hosts of various ehrlichial species. Although E. chaffeensis and A. phagocytophilum can cause persistent infections in animals, documentation of chronic infections in humans is exceedingly rare. Transmission of Ehrlichia can occur within hours of tick attachment, in contrast to the 1-2 days of attachment required for transmission of B. burgdorferi to occur. Transmission of A. phagocytophilum is via the bite of the small nymphal stage of Ixodes spp., including I. scapularis (see Fig. 220-1), which is very active during late spring and early summer in the eastern USA.
Pathology and Pathogenesis
Although human monocytic ehrlichiosis and anaplasmosis often clinically mimics RMSF or typhus, vasculitis is rare. Pathologic findings include mild, diffuse perivascular lymphohistiocytic infiltrates; Kupffer cell hyperplasia; mild lobular hepatitis with infrequent apoptotic hepatocytes; infiltrates of mononuclear phagocytes in the spleen, lymph nodes, and bone marrow with occasional erythrophagocytosis; granulomas of the liver and bone marrow in patients with E. chaffeensis infections; and hyperplasia of one or more bone marrow hematopoietic lineages.
The exact pathogenetic mechanisms are poorly understood, but histopathologic examinations suggest diffuse mononuclear phagocyte activation and poorly regulated host immune and inflammatory reactions. This activation results in moderate to profound leukopenia and thrombocytopenia despite a hypercellular bone marrow, and deaths often are related to severe hemorrhage or secondary opportunistic infections. Hepatic and other organ-specific injury occurs by an unknown mechanism that appears to be unrelated to direct infection. Meningoencephalitis with a mononuclear cell pleocytosis in the cerebrospinal fluid (CSF) occurs with HME but is rare with HGA.
Clinical Manifestations
The clinical manifestations of HME, HGA, and ewingii ehrlichiosis are similar. Many well-characterized infections of HME and HGA of variable severity have been reported in children, including 1 death each from HME and HGA. Children with ehrlichiosis are often ill for 4-12 days, shorter than in adults. In series of children with HME, most required hospitalization and many (25%) required intensive care; this might represent preferential reporting of severe cases. Population-based studies have documented that seroconversion often occurs in children who are well or who have only a mild illness.
Fewer pediatric cases of E. ewingii infection are reported, so the clinical manifestations related to this infection are less well characterized. However, in adults E. ewingii and monocytic ehrlichiosis are clinically similar. The incubation period (time from last tick bite or exposure) appears to range from 2 days to 3 wks. Nearly 25% of patients do not report a tick bite. Clinically, the ehrlichioses are nonspecific illnesses. Fever (~100%) and headache (~75%) are most common, but many patients also report myalgias, anorexia, nausea, and vomiting. With HME, rash is more common in children (nearly 66%) than in adults (33%). The rash is usually macular or maculopapular, but petechial lesions can occur. Photophobia, conjunctivitis, pharyngitis, arthralgias, and lymphadenopathy are less consistent features. Hepatomegaly and splenomegaly are detected in nearly 50% of children with ehrlichiosis. Edema of the face, hands, and feet occurs more commonly in children than in adults, but arthritis is uncommon in both groups.
Meningoencephalitis with a lymphocyte-predominant CSF pleocytosis is an uncommon but potentially severe complication of HME that appears to be rare with HGA. CSF protein may be elevated and glucose may be mildly depressed in adults with HME meningoencephalitis, but CSF protein and glucose in affected children are typically normal. In 1 series, 19% of adult patients with CNS symptoms and abnormal CSF died despite normal CTs of the brain.
Laboratory Findings
Characteristically, most children with monocytic ehrlichiosis present with leukopenia (58-72%), lymphopenia (75-78%), and thrombocytopenia (80-92%); cytopenias reach a nadir several days into the illness. Lymphopenia is common in both HME and HGA, and neutropenia is reported in adults with HGA. Leukocytosis can also occur. Despite the presence of pancytopenia, examination usually reveals a cellular or reactive bone marrow in adults. Interestingly, granulomas and granulomatous inflammation are identified in nearly 75% of bone marrow specimens examined from patients with proven cases of E. chaffeensis infection, but this finding is not present in patients with HGA. Mild to severe hepatic injury is documented by the common (83-91%) finding of elevated serum transaminase levels. Hyponatremia (<135 mEq/L) is present in most cases. Kidney involvement in children manifests as elevated levels of serum creatinine and blood urea nitrogen. A clinical picture similar to disseminated intravascular coagulopathy has also been reported.
Diagnosis
A delay in diagnosis or treatment can contribute to increased morbidity or mortality; thus, treatment must be begun early based on clinical suspicion. Because both HME and anaplasmosis can cause death, therapy should not be withheld while waiting for the results of confirmatory testing. In fact, prompt response to therapy supports the diagnosis.
The 1st patient and several subsequent pediatric patients with E. chaffeensis infection were identified presumptively on the basis of typical Ehrlichia morulae in peripheral blood leukocytes (Fig. 223-1A). This finding has been too infrequent to be considered a useful diagnostic tool. In contrast, HGA presents with a small but significant percentage (1-40%) of circulating neutrophils (Fig. 223-1B) containing typical morulae in 20-60% of patients. The distinction between the 2 infections relies on polymerase chain reaction (PCR) amplification of species-specific DNA sequences or on the demonstration of specific antibodies to E. chaffeensis or A. phagocytophilum with low titer or absent antibodies to the other agent.
Figure 223-1 Morulae in peripheral blood leukocytes in patients with human monocytic ehrlichiosis and human granulocytic anaplasmosis. A, A morula (arrow) containing Ehrlichia chaffeensis in a monocyte. B, A morula (arrowhead) containing Anaplasma phagocytophilum in a neutrophil. Wright stains, original magnifications ×1,200. E. chaffeensis and A. phagocytophilum have similar morphologies but are serologically and genetically distinct.
Diagnostic criteria can confirm or suggest ehrlichioses in a clinically compatible case. E. chaffeensis and A. phagocytophilum infections can be confirmed by demonstrating a fourfold change in IgG titer by indirect immunofluorescence assay (IFA) between paired sera or detection of specific DNA by PCR or demonstration of ehrlichial antigen in a tissue sample by immunohistochemistry or isolation of the organism in cell culture. A single specific titer of ≥64 or identification of morulae in monocytes or macrophages for E. chaffeensis or in neutrophils or eosinophils for A. phagocytophilum by microscopy is suggestive. Ehrlichia ewingii can only be confirmed by PCR, because it has not been cultured and antigens are not available. E. ewingii infection induces antibodies that cross react with E. chaffeensis in routine serologic tests and can only be differentiated by identification of specific nucleic acids. Patients with HGA have serologic reactions to E. chaffeensis in up to 15% of cases, and thus serodiagnosis depends on testing with both E. chaffeensis and A. phagocytophilum antigens and demonstrating a 4-fold or higher difference between titers. During the acute phase of illness when antibodies might not be detected, PCR amplification of specific E. chaffeensis or A. phagocytophilum DNA sequences is sensitive in 50-86% of cases. Although E. chaffeensis and A. phagocytophilum have both been cultivated in tissue culture, this method does not provide a timely result.
Differential Diagnosis
Because of the nonspecific presentation, ehrlichiosis mimics other arthropod-borne infections such as RMSF, tularemia, babesiosis, Lyme disease, murine typhus, relapsing fever, and Colorado tick fever. Other potential diagnoses often considered include otitis media, streptococcal pharyngitis, infectious mononucleosis, Kawasaki disease, endocarditis, respiratory or gastrointestinal viral syndromes, hepatitis, leptospirosis, Q fever, collagen-vascular diseases, and leukemia. If rash and disseminated intravascular coagulopathy predominate, meningococcemia, bacterial sepsis, and toxic shock syndrome are also suspected. Meningoencephalitis might suggest aseptic meningitis due to enterovirus or herpes simplex virus, bacterial meningitis, or RMSF. Severe respiratory disease may be confused with bacterial, viral, and fungal causes of pneumonia.
Treatment
Both HME and HGA are effectively treated with tetracyclines, especially doxycycline, and the majority of patients usually improve within 48 hr. In vitro tests document that both E. chaffeensis and A. phagocytophilum have minimal inhibitory concentrations to chloramphenicol above blood levels that can be safely achieved. Therefore, a short course of doxycycline is the recommended regimen. Doxycycline can be used safely in children <8 yr of age because tooth discoloration is dose dependent and the need for multiple courses is unlikely. Few data exist to recommend alternative therapies; however, both E. chaffeensis and A. phagocytophilum are susceptible in vitro to rifampin, which has been used successfully to treat HGA in pregnant women and children.
The recommended regimen for patients of all ages with severe or complicated HME and HGA is doxycycline (4 mg/kg/day PO or IV divided every 12 hr, maximum dose 200 mg/day). An alternative regimen is tetracycline 25-50 mg/kg/day divided every 6 hr PO, maximum 2 g/day. Therapy should be continued for ≥5 days and until the patient has been afebrile for ≥2-4 days.
Other broad-spectrum antibiotics, including penicillins, cephalosporins, aminoglycosides, and macrolides, are not effective. In vitro studies suggest that fluoroquinolones are active against A. phagocytophilum, although at least one patient relapsed when levofloxacin was discontinued. E. chaffeensis is naturally resistant to fluoroquinolones owing to a single nucleotide change in gyrA, which suggests that A. phagocytophilum could also become resistant to fluoroquinolones rapidly.
Complications and Prognosis
Fatal monocytic ehrlichiosis has been reported in 1 pediatric patient where the findings were initially dominated by pulmonary involvement with respiratory failure complicated by nosocomial bacterial pneumonia. The pattern of severe pulmonary involvement culminating in diffuse alveolar damage and acute respiratory distress syndrome (ARDS) and secondary nosocomial or opportunistic infections is now well documented with HME and HGA in adults. One child with HGA died after 3 wk of fever, thrombocytopenia, and lymphadenopathy suspected to be a hematologic malignancy. Other severe complications include a toxic shock–like illness, meningoencephalitis with long-term neurologic sequelae, brachial plexopathy, demyelinating polyneuropathy, myocarditis, rhabdomyolysis, and renal failure. Patients who are immunocompromised (e.g., HIV infection, high-dose corticosteroid therapy, cancer chemotherapy, immunosuppression for organ transplantation) are at high risk for fulminant E. chaffeensis infection.
Prevention
HME, HGA, and ewingii ehrlichiosis are tick-borne diseases, and any activity that increases exposure to ticks increases risk. Avoiding tick-infested areas, wearing appropriate light-colored clothing, spraying tick repellents on clothing, carefully inspecting for ticks after exposure, and promptly removing any attached ticks diminish the risk of HME and HGA. The interval between tick attachment and transmission of the agents may be as short as 4 hr; thus, any attached tick should be removed promptly. The role of prophylactic therapy for ehrlichiosis and anaplasmosis after tick bites has not been investigated. It is not known if infection confers protective immunity; however, reinfection appears to be exceedingly rare.
Arnez M, Luznik-Bufon T, Avsic-Zupanc T, et al. Causes of febrile illnesses after a tick bite in Slovenian children. Pediatr Infect Dis J. 2003;22:1078-1083.
Berry DS, Miller RS, Hooke JA, et al. Ehrlichial meningitis with cerebrospinal fluid morulae. Pediatr Infect Dis J. 1999;18:552-555.
Buller RS, Arens M, Hmiel SP, et al. Ehrlichia ewingii, a newly recognized agent of human ehrlichiosis. N Engl J Med. 1999;341:148-155.
Centers for Disease Control and Prevention. Anaplasmosis and ehrlichiosis—Maine, 2008. MMWR Morb Mortal Wkly Rep. 2010;58:1033-1036.
Dumler JS, Dey C, Meier F, et al. Human monocytic ehrlichiosis: a potentially severe disease in children. Arch Pediatr Adolesc Med. 2000;154:847-849.
Hamburg BJ, Storch GA, Micek ST, et al. The importance of early treatment with doxycycline in human ehrlichiosis. Medicine. 2008;87:53-60.
Horowitz HW, Kilchevsky E, Haber S, et al. Perinatal transmission of the agent of human granulocytic ehrlichiosis. N Engl J Med. 1998;339:375-378.
Jacobs RF. Human monocytic ehrlichiosis: similar to Rocky Mountain spotted fever but different. Pediatr Ann. 2002;31:180-184.
Jacobs RF, Schutze GE. Ehrlichiosis in children. J Pediatr. 1997;131:184-192.
Krause PJ, Corrow CL, Bakken JS. Successful treatment of human granulocytic ehrlichiosis in children using rifampin. Pediatrics. 2003;112:e252-e253.
Lantos P, Krause PJ. Ehrlichiosis in children. Semin Pediatr Infect Dis. 2002;13:249-256.
Marshall GS, Jacobs RF, Schutze GE, et al. Ehrlichia chaffeensis seroprevalence among children in the southeast and south-central regions of the United States. Arch Pediatr Adolesc Med. 2002;156:166-170.
Moss WJ, Dumler JS. Simultaneous infection with Borrelia burgdorferi and human granulocytic ehrlichiosis. Pediatr Infect Dis J. 2003;22:91-92.
Olano JP, Walker DH. Human ehrlichiosis. Med Clin North Am. 2002;86:375-392.
Peters TR, Edwards KM, Standaert SM. Severe ehrlichiosis in an adolescent taking trimethoprim-sulfamethoxazole. Pediatr Infect Dis J. 2000;19:170-172.
Schutze GE. Ehrlichiosis. Pediatr Infect Dis J. 2006;25:71-72.
Schutze GE, Buckingham SC, Marshall GS, et al. Human monocytic ehrlichiosis in children. Pediatr Infect Dis J. 2007;26:475-479.
Stone JH, Dierberg K, Aram G, et al. Human monocytic ehrlichiosis. JAMA. 2004;292:2263-2270.
Zhang L, Shan A, Mathew B, et al. Rickettsial seroepidemiology among farm workers, Tianjin, People’s Republic of China. Emerg Infect Dis. 2008;14:938-940.